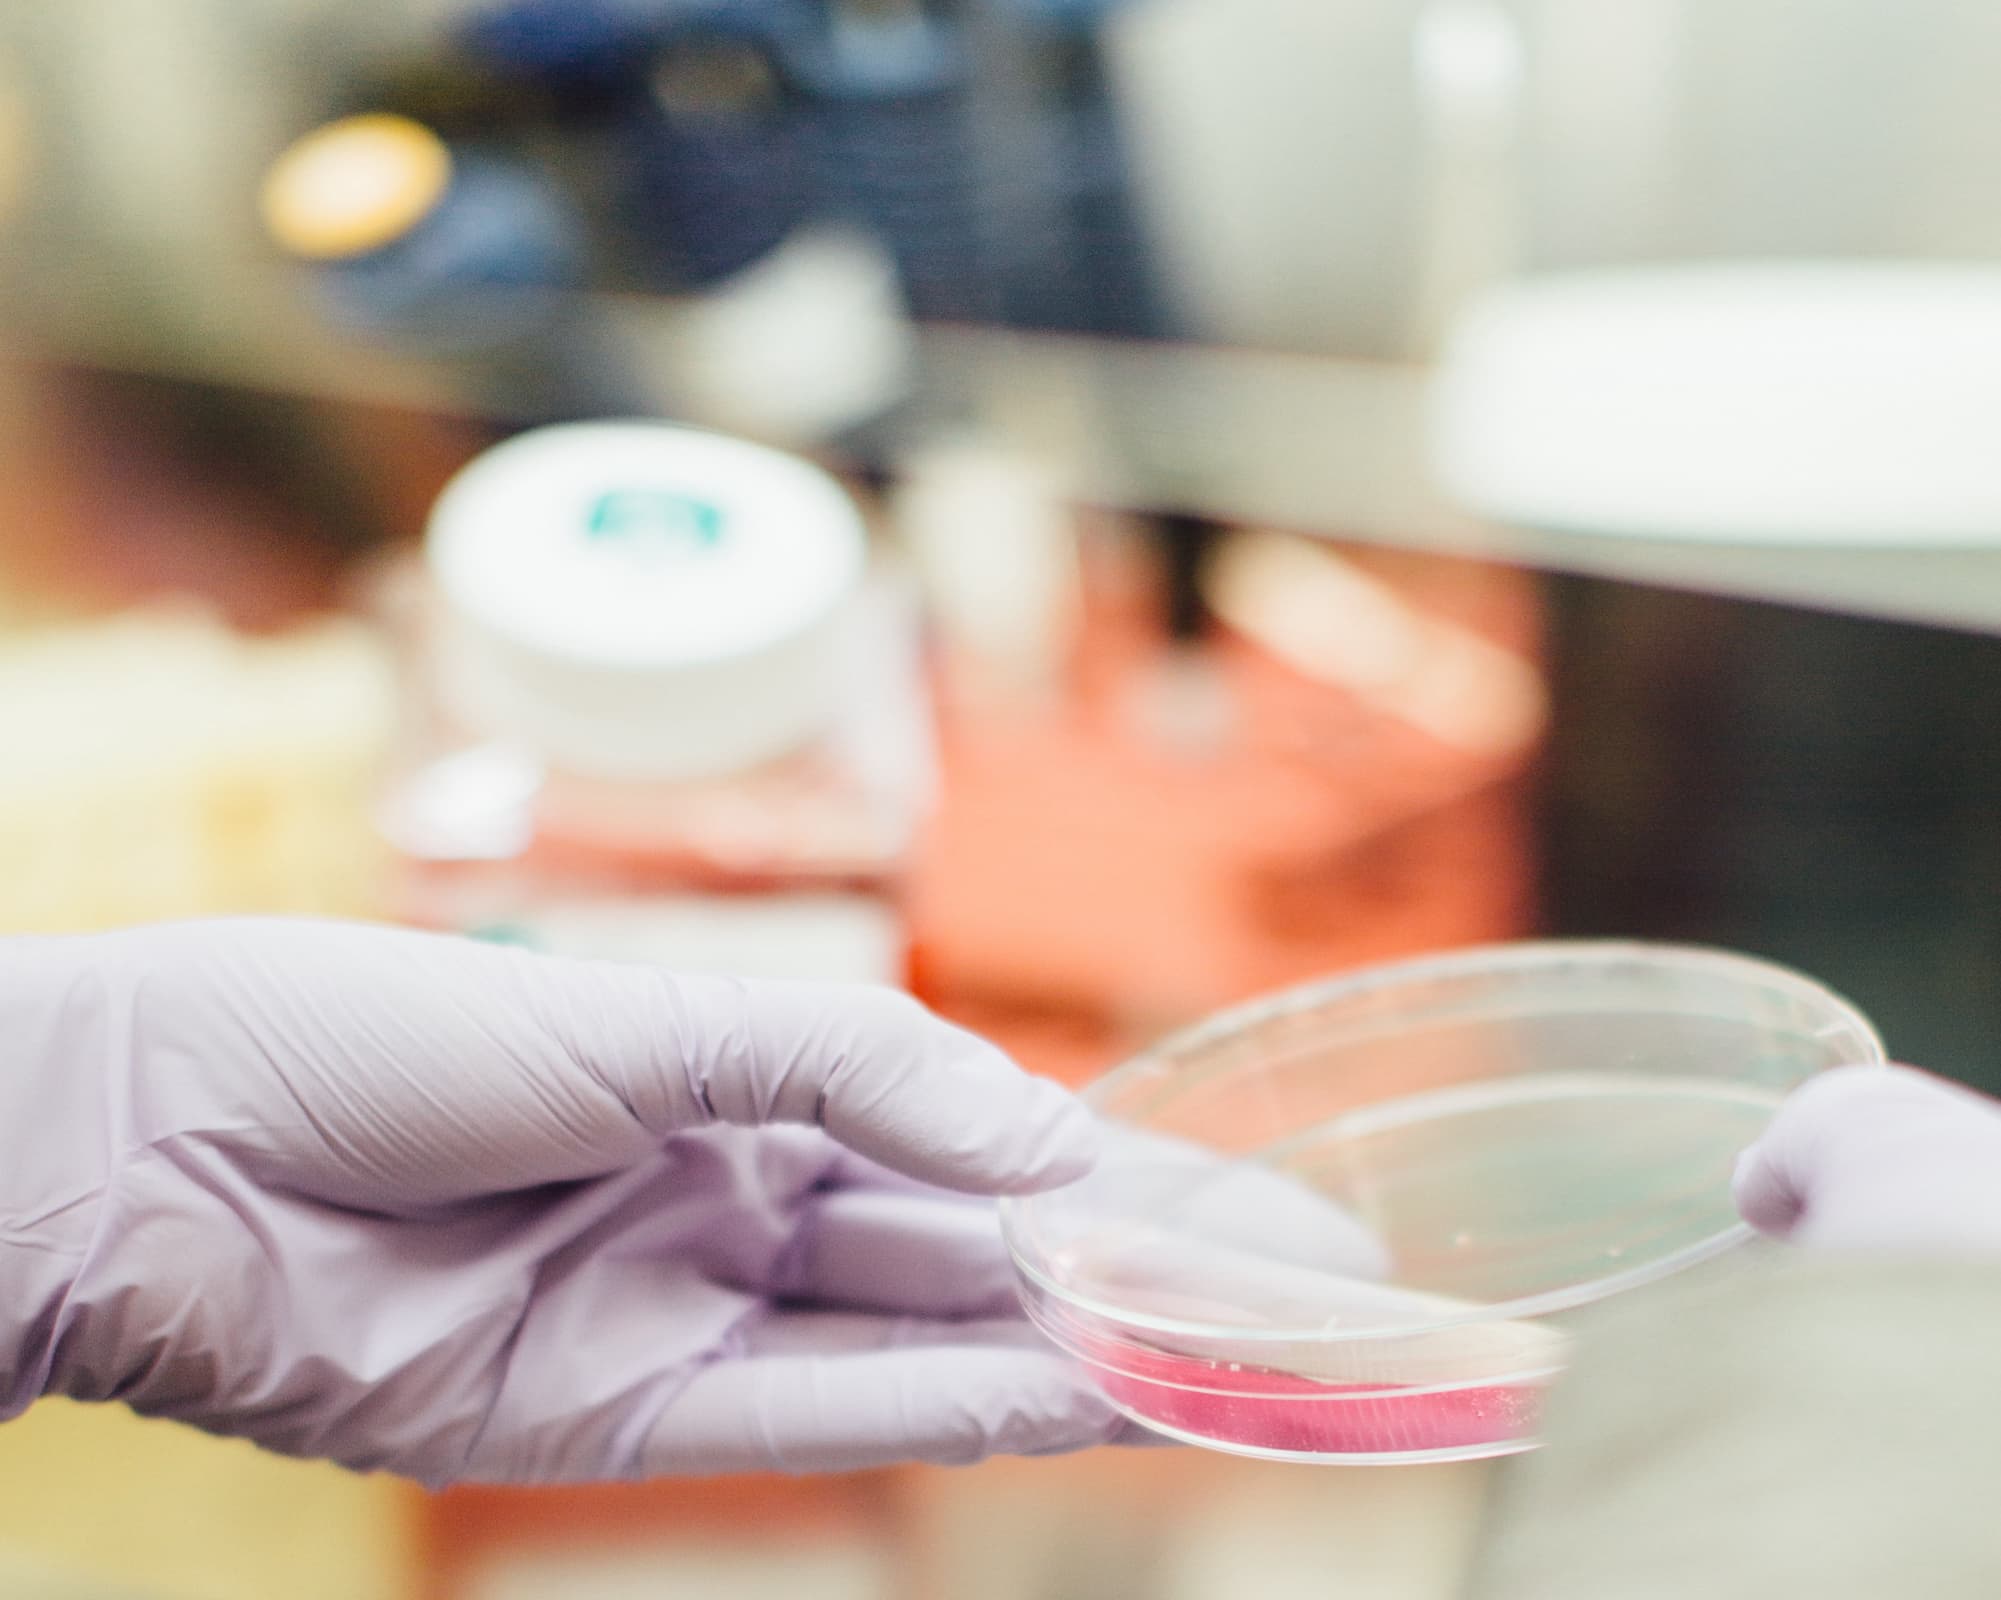

Designed for business teams like yours
At EISD Inc., we specialize in Enterprise Performance Management (EPM) solutions designed to empower business teams like yours. We focus on markets where technology, innovation, and capital converge to unlock long-term value and stimulate economic growth.
Strategic Financial Planning
Utilize EPM for long-term strategic planning, enhancing forecasting accuracy, and ensuring agility in adapting to market changes.
Efficient Financial Consolidation
Streamline financial consolidation processes with EPM, ensuring compliant and insightful financial reporting to drive informed decision-making
Robust Budgeting and Forecasting
Implement robust budgeting processes and improve accuracy in financial forecasting, empowering businesses to make informed financial decisions
Performance Analytics
Leverage EPM for performance analytics, allowing businesses to define and monitor Key Performance Indicators (KPIs) for informed decision-making.
Business Process Automation
Streamline workflows with EPM automation, enhancing operational efficiency through automated task assignments and process optimization.
Make Better Decisions
Conduct scenario modeling using EPM for strategic decision-making, analyzing various business scenarios to inform planning and mitigate risks
Some of our top Clients:
Our success has come from being committed to the quality and solving complex business process. At the same time and maintaining the integrity.